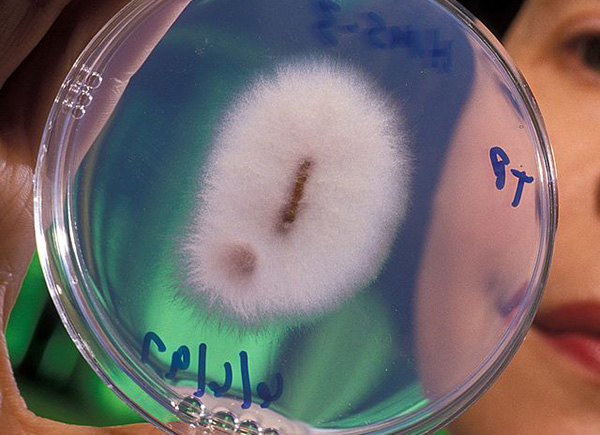

La banane, victime d’un champignon ravageur, n’a pas la pêche
Les plantations asiatiques de bananes ne se portent pas bien actuellement. En cause, le retour d’un champignon ravageur qui détruit ces plantes herbacées : la maladie de Panama.

Si on consomme près de 268.000 tonnes de bananes à l’année en France, les plantations de bananes luttent contre un fléau sur le retour : la jaunisse fusarienne, ou maladie de Panama.
La maladie de Panama menace la banane
On l’appelle aussi maladie de Panama ou encore Fusariose du bananier mais, quelle que soit son appellation, la FAO avait déjà prévenu en avril 2014 qu’elle « pourrait avoir de sérieuses conséquences pour les planteurs, les négociants et les familles qui tirent leurs moyens d’existence de la filière bananière« . Aujourd’hui, l’organisation de l’ONU pour l’alimentation et l’agriculture, demande 98 millions de dollars pour éviter et de faire face à sa progression dans 67 pays, alors qu’elle a déjà décimé près de 100.000 hectares de bananiers, principalement en Asie.
Il s’agit d’une maladie ravageuse pour les plantations de banane, qui se présente sous la forme d’un champignon très résistant, Fusarium oxysporum.
Du rififi dans les plantations, pas dans votre assiette
Le bon côté est que le fruit reste comestible. Le mauvais côté, et il n’est pas des moindres, est que le champignon réduit fortement la production, en endommageant les bananiers de manière importante.
Lorsque le champignon contamine les plants de bananes, les bananiers se dessèchent et prennent une couleur marron-jaune pour enfin dépérir. Les plantations deviennent alors inutilisables. « À ce jour, Tropical Race 4 (TR4) a sans doute affecté environ 100.000 hectares en 20 ans, et il est vraisemblable qu’il va continuer à se disséminer davantage« , estiment les auteurs et scientifiques de l’Université de Wageningen aux Pays-Bas.

© FAO
La FAO alerte : la maladie de Panama « risque de décimer l’ensemble de la production mondiale de bananes, ce qui entraînerait d’importantes pertes commerciales et aurait des répercussions sur les moyens d’existence de 400 millions de personnes qui dépendent du fruit le plus exporté au monde pour se nourrir ou en tirer leurs revenus« .
Les Cavendish particulièrement en danger
La plus populaire des espèces de banane est menacée par la maladie de Panama, un pathogène résistant aux fongicides qui a traversé tous les continents et qui se propage actuellement au sud de l’Asie, en Afrique, au Moyen-Orient et en Australie. Selon une étude réalisée par des chercheurs aux Pays-Bas, ce pathogène va bientôt traverser l’océan et débarquer en Amérique du Sud, qui produit 82 % des bananes Cavendish qui est l’espèce la plus populaire au monde. Un marché de plusieurs dizaines de milliards est en jeu.(1)

D’après un rapport de France Agrimer, en France en 2016, 30 % de l’approvisionnement provenait des Antilles ; 50 % des pays ACP (Afrique, Caraïbes, Pacifique) et un peu plus de 13 % d’Amérique latine(2).
C’est ce type d’épidémie importante qui avait poussé la France à rendre légal le chlordécone, moyen de lutte contre le charançon, avec les dégâts que l’ont sait sur la santé en Martinique.
Gert Kema, spécialiste des bananes, et ses collègues préconisent un renforcement et une amélioration des mesures pour empêcher le TR4 de gagner encore plus de terrain : « Notre recherche démontre que les mesures de quarantaine et d’information prises à travers le monde n’ont apparemment pas eu l’effet désiré« .
Pour l’heure, les producteurs de bananes misent sur la pulvérisation de fongicide tous les six jours. Mais des risques pour la santé humaine sont à prévoir et le coût de ce traitement est cher et de nombreux petits producteurs n’y ont pas accès.
Les scientifiques travaillent donc à trouver de nouvelles variétés de bananes capables de résister à ce champignon. Ils ont notamment donné naissance à la banane Goldfinger, une variété capable de résister à différentes maladies dont celle provoquée par le TR4. Aujourd’hui, cette variété de banane n’est présente que sur certains marchés, en Australie notamment, et n’a pas réussi à gagner du terrain.
La saison 2018 en France
La filière banane n’est pas au bout de ses peines : en effet, les derniers ouragans ont entraîné d’énormes dégâts, au point que 100 % des bananeraies ont été détruites en Guadeloupe et 70 % en Martinique. En métropole, après le beurre, on pourrait se trouver en pénurie, mais cela ne sera pas pour cette fin d’année. En effet, la France peut compter sur d’autres exportateurs dont les plantations n’ont pas (encore) été contaminées.
Illustration bannière : Bananes – © ch_ch
A lire absolument
































IL Y A AUSSI EU EPANDAGE DE CHLORDECONE EN GUADELOUPE………….. ET PAS QU’EN MARTINIQUE !!!!!!!!!!!
Tous ces articles sont très intéressants et excellents.J’ai appris beaucoup en les lisant soigneusement. merci